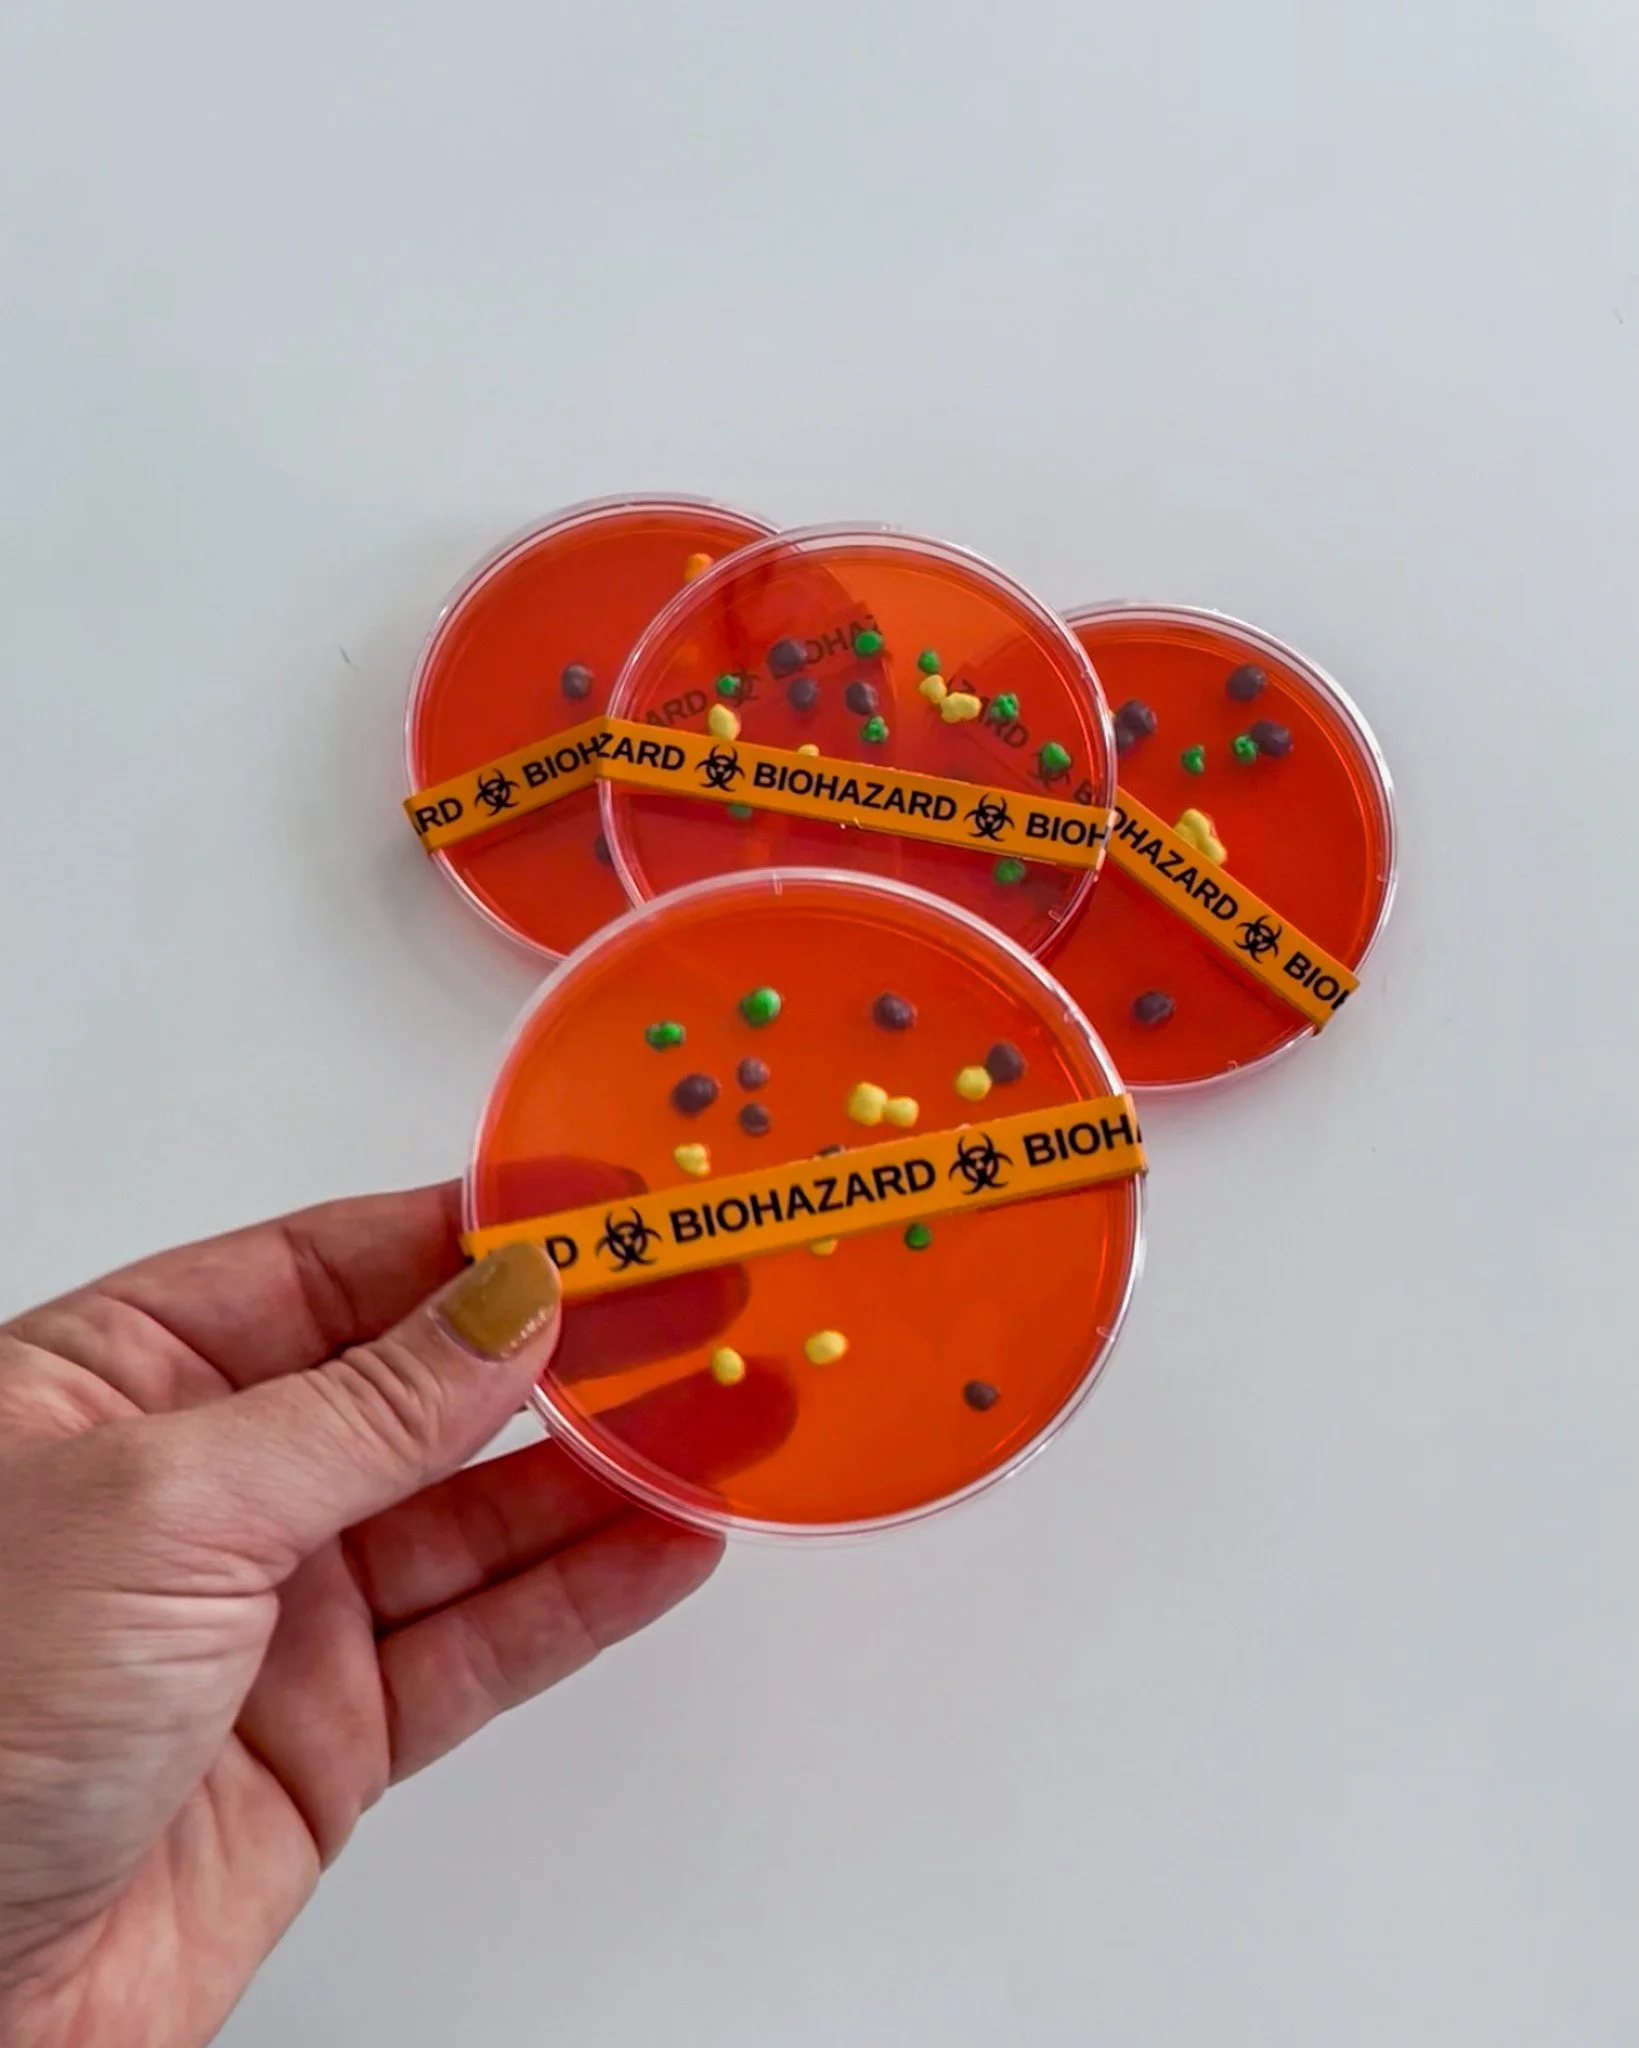

DIY Petri Dish Jello Shots for Halloween
Hi fiends!
A few years ago, we made these Petri dish germ jello shots for a Halloween party we were attending, and they turned out to be an absolute crowd-pleaser that everyone couldn’t stop talking about. Everyone loved them, and the best part was how incredibly easy and quick they were to make! I wanted to share exactly how we made them and where we found all the supplies so you can easily try them out too without any hassle! These DIY Petri Dish Jello Shots are the perfect themed adult beverage to serve at your Halloween party this year. They are the ideal balance between spooky and playful, adding a fun and creative twist to your get together that your guests will remember {or not remember} long after the night is over!
Happy reading!
What You’ll Need
Supplies:
Small clear plastic Petri dishes (food-safe)
Plastic pipettes or syringes (optional, but add major lab vibes)
Tray or baking sheet for easy transport
Ingredients:
Jello mix (think eerie shades like lime green, blood red, electric blue, or deep purple)
Vodka (or your clear spirit of choice, substitute water for a non-alcoholic version)
Cold water
Nerds which look like “germs”, gummy worms, gummy eyeballs, or other creepy candy add-ins!
Caution tape to close the petri dishes
Step-by-Step Instructions
Mix Your Jello Base
Basically make your Jello according to the package directions, but replace half the cold water with vodka (or keep it kid-friendly with just water).Pour into Petri Dishes
Carefully fill each dish about halfway. I put them on a tray so that they were easier to move to the fridge without spilling or making a giant mess.Add Your “Specimens”
Before the Jello sets completely, this is when you drop in the extras! I used nerds because they looked like germs but you can also use things like gummy worms, candy eyeballs, or even like swirls of food coloring to mimic the look of bacteria.Chill Until Firm
Put the tray back into the fridge and let the Jello set completely.Ready to Serve! Chill Until Firm
I wouldn’t let these sit for more than 6 hours before serving to guests. We had a couple that we didn’t take to the party and the nerds coloring ran into the jello and it looked weird. I would say making these closer to the party is best! If you need to make them further in advance than this, then I would opt out of adding in the candy extras and they will last a lot longer!
Serving & Presentation
The cool/wow factor is really all in the presentation! Here are some easy ideas that you can do to really take it up a notch:
You can serve the Petri dishes on a tray that is lined with dry ice for a smoky, “mad-scientist” effect!
You can pair them with syringe shots filled with the same jello to add to the Halloween science lab theme!
Just have fun with it and make it yours!
Fun Variations
Non-alcoholic Petri dishes: Perfect for kids’ parties, just skip the vodka step!
Create a layered look: I’ve never tried this but you can add two or three layers of different Jello colors!
Halloween is like the one time of year where grossish food is not only accepted but really it’s like celebrated. These DIY Petri Dish Jello Shots will definitely get laughs before your guests dig in to try one! Whether you keep them kid-friendly or spiked for the adults, they’re really simple to put together but look really cool and are a fun addition to your spooky spread. There's seriously no wrong way to do it so put your own fun twist on it! Also, if you have any Halloween party snacks or drinks you like to make share them below so others can make them too! Other than that, if you have any questions at all you can also email me at hello@emmatarynjones.com and I will get back to you as soon as possible!
Emma